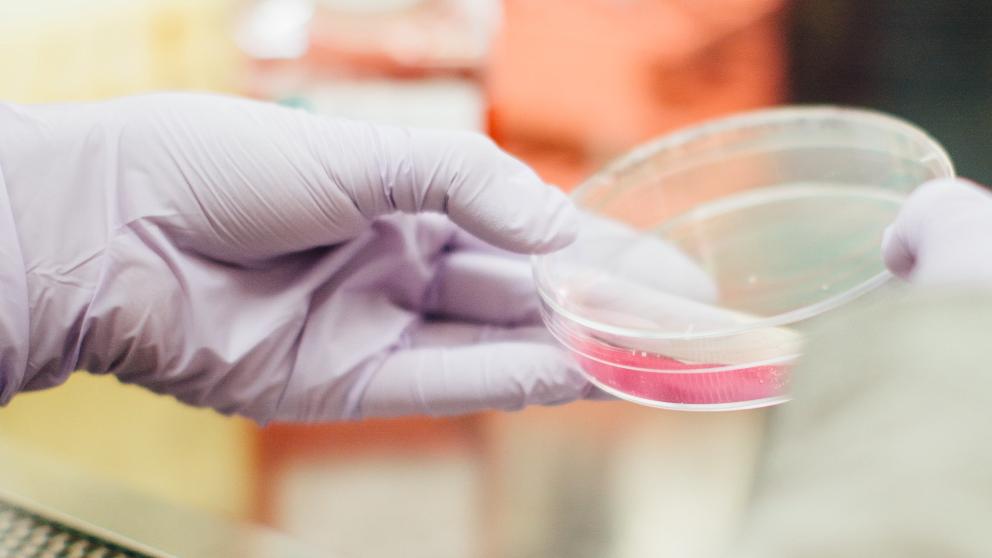
Lab Work

Female Salford Scientist inspiring the future
As part of International Women’s Day (March 8) celebrations, The University of Salford has taken the opportunity to tackle the stigmas surrounding gender imbalance in STEM (science, technology, engineering, and mathematics) subjects by highlighting some of the remarkable work done by Salford’s female academics.
The work of Professor Haifa Takruri MBE has proved invaluable in inspiring young women to pursue careers in STEM, in which they are historically underrepresented. Professor Takruri is an academic leader at the School of Science, Engineering and Environment, as well as a recognised advocate for equality and diversity.
She started her remarkable career as a lecturer and has since led countless initiatives alongside conducting research to address the under-representation of women in STEM, in particular engineering. The research included investigating workplace cultures and practices which lead to a lack of recruitment, retention, and progression of women in engineering.
Explaining why women are underrepresented in STEM, she said: “STEM professions clearly suffered over generations, and still suffer from a number of misconceptions relating to its content and diversity. The misconceptions and stereotypes of what subjects and careers are suitable for women and men still exist.
“When I was growing up as a child, I went to all girls' schools. Those were the only schools available in my home country of Palestine. My parents and teachers always encouraged me to excel. I was very good at and loved maths and science subjects and no one told me not to!”
She has been the recipient of many accolades, including an MBE for services to Women, Black and Minority Ethnic people in Science, Engineering and Technology Education, and in 2010 she was awarded the Ministry of Defence sponsored Muslim News award for excellence in Science, Engineering and Technology.
When commenting on the role of women working in STEM subjects, she said: “Women in particular can benefit from seeing how the work of engineers and scientists develop wider society. If women are provided with a better understanding of the different options in STEM and see how it relates to the world in which we live, they may be more likely to follow STEM as a career.
“It’s very important to be able to relate to like-minded people who share similar journeys and experiences, and have similar responsibilities at home and at work, hence the importance of role models who have progressed and succeeded in the field. To be reflected in the media is very important, especially to young people, as the media is a very influential tool that affects the direction of young people.”
Professor Takruri is active in organising events to raise the awareness of women in STEM and emphasised: “We should be celebrating the achievements, contributions, and successes of women in STEM to inspire the next generations.”
Below: Professor Takruri

For all press office enquiries please email communications@salford.ac.uk.
Share:
